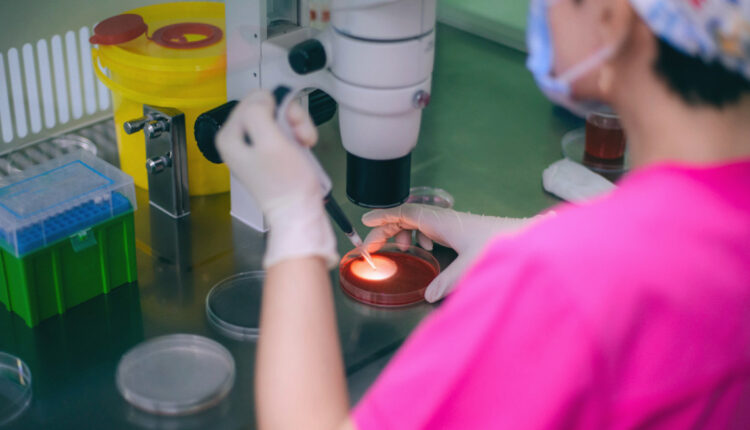

Σοκ στην Ευρώπη: Δωρητής σπέρματος με μετάλλαξη για καρκίνο «γέννησε» 196 παιδιά
Έρευνα αποκαλύπτει ότι ο άνδρας, φορέας σπάνιας γενετικής μετάλλαξης, πούλησε σπέρμα για 17 χρόνια, με ορισμένα παιδιά να έχουν ήδη πεθάνει.
Μια συγκλονιστική δημοσιογραφική έρευνα, στην οποία συμμετείχαν 14 οργανισμοί, αποκάλυψε την περίπτωση ενός δωρητή σπέρματος που ήταν φορέας μιας γενετικής μετάλλαξης, η οποία αυξάνει δραματικά τον κίνδυνο καρκίνου. Ο άνδρας αυτός φέρεται να «γέννησε» τουλάχιστον 196 παιδιά σε όλη την Ευρώπη. Σύμφωνα με το BBC, που συμμετείχε στην έρευνα, ορισμένα από αυτά τα παιδιά έχουν ήδη χάσει τη ζωή τους, ενώ μόνο ένα μικρό ποσοστό εκείνων που κληρονόμησαν τη μετάλλαξη θα καταφέρουν να αποφύγουν τον καρκίνο κατά τη διάρκεια της ζωής τους.
Η Ευρωπαϊκή Τράπεζα Σπέρματος της Δανίας, η οποία πούλησε το επίμαχο σπέρμα, εξέφρασε τη «βαθιά συμπάθειά» της προς τις οικογένειες που επηρεάστηκαν. Παραδέχτηκε, δε, ότι το σπέρμα χρησιμοποιήθηκε για τη γέννηση υπερβολικά πολλών μωρών σε ορισμένες χώρες, περιλαμβανομένης και της Ελλάδας, όπως δείχνει ένας χάρτης του BBC.
Το σπέρμα προήλθε από έναν ανώνυμο άνδρα, ο οποίος είχε προσληφθεί ως δωρητής ενώ ήταν φοιτητής, ξεκινώντας το 2005, και χρησιμοποιήθηκε για τη γέννηση παιδιών για περίπου 17 χρόνια. Αν και ο άνδρας είχε περάσει τους αρχικούς ελέγχους των δωρητών, η μετάλλαξη στο DNA του εμφανίστηκε πριν από τη γέννησή του.
Η μετάλλαξη αυτή, όπως επισημαίνει το BBC, προκάλεσε βλάβη στο γονίδιο TP53, το οποίο είναι κρίσιμο για την αποτροπή της δημιουργίας καρκινικών κυττάρων. Ενώ το μεγαλύτερο μέρος του σώματος του δότη δεν έφερε την επικίνδυνη μορφή του TP53, έως και το 20% του σπέρματός του την περιείχε. Τα παιδιά που γεννήθηκαν από αυτό το σπέρμα κληρονόμησαν τη μετάλλαξη σε κάθε κύτταρο του σώματός τους. Αυτό είναι γνωστό ως σύνδρομο Li Fraumeni και αυξάνει την πιθανότητα εμφάνισης καρκίνου έως και 90%, ιδίως κατά την παιδική ηλικία, ενώ αυξάνει και τον κίνδυνο για καρκίνο του μαστού σε μεταγενέστερη ηλικία.
«Είναι μια τρομερή διάγνωση, ένα βαρύ φορτίο που κουβαλούν οι οικογένειες για όλη τους τη ζωή, ζώντας με αυτόν τον κίνδυνο», σχολίασε η γενετίστρια καρκίνου στο Ινστιτούτο Έρευνας Καρκίνου του Λονδίνου, Κλείρ Τέρνμπουλ.
Η Ευρωπαϊκή Τράπεζα Σπέρματος ανέφερε ότι ο δότης και η οικογένειά του δεν είναι άρρωστοι, προσθέτοντας ότι τέτοιου είδους μεταλλάξεις δεν ανιχνεύονται προληπτικά με γενετικό έλεγχο. Δήλωσε, δε, ότι απέκλεισαν αμέσως τον δότη μόλις έγινε γνωστό το πρόβλημα.
Η υπόθεση άρχισε να αποκαλύπτεται όταν γιατροί που παρακολουθούσαν παιδιά με καρκίνο, ο οποίος συνδεόταν με τη δωρεά σπέρματος, εξέφρασαν τις ανησυχίες τους στην Ευρωπαϊκή Εταιρεία Ανθρώπινης Γενετικής. Είχαν εντοπίσει 23 παιδιά με τη μετάλλαξη από τα 67 γνωστά τότε, εκ των οποίων τα δέκα είχαν ήδη διαγνωστεί με καρκίνο.
Η έρευνα αναφέρει ότι ο συνολικός αριθμός των επηρεαζόμενων παιδιών είναι τουλάχιστον 197, αλλά ο αριθμός ενδέχεται να αυξηθεί, καθώς δεν έχουν συμπεριληφθεί δεδομένα από όλες τις χώρες. Επιπλέον, δεν είναι γνωστό πόσα από αυτά τα παιδιά κληρονόμησαν την επικίνδυνη παραλλαγή.